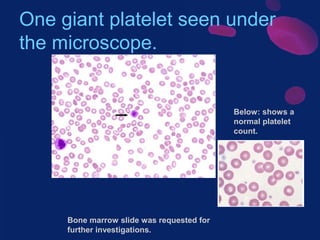
One giant platelet seen under
the microscope.

Below: shows a
normal platelet
count.

Bone marrow slide was requested for
further investigations.

This document discusses thrombocytopenic purpura (TP), a condition characterized by low platelet count and bruising. It describes the main types of TP, including immune (idiopathic) TP, thrombotic thrombocytopenic purpura, and drug-induced TP. Epidemiology and pathogenesis are covered. A case study demonstrates the clinical presentation and diagnosis of a 12-year-old male with immune thrombocytopenic purpura. Treatment options are outlined, including steroids, immunoglobulins, thrombopoietin receptor agonists, and splenectomy. Differential diagnoses and references are also provided.